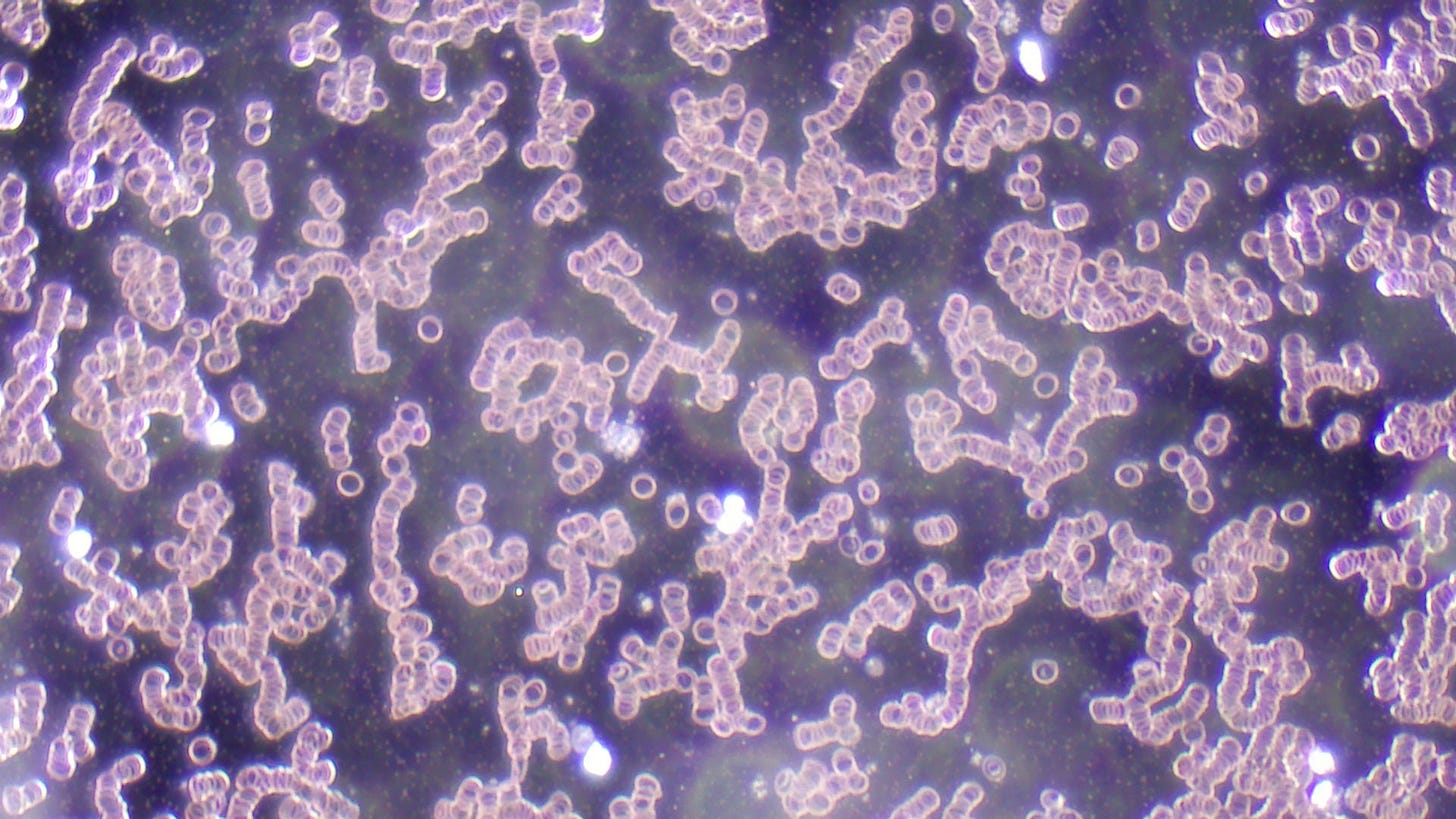

Blood under the Microscope after 16 days of Liposomal EDTA and Vitamin C
After taking liposomal EDTA and liposomal Vitamin C for 16 days, I rechecked my blood and found no hydrogels:
But there was quite a bit of red blood cell aggregation:
I was a bit dehydrated and so I drank 16 oz of water and walked in my yard barefoot for around 10 minutes and rechecked my blood:
It is not optimal but better. I didn’t find any hydrogel/mesogen but I did find this:
According to what I have learned this could be accumulated protein which can occur as a result of inflammation. I’m still battling Graves disease, an auto-immune hyperthyroid condition, which goes hand in hand with inflammation. Proteins can also occur if leaky gut is present, but I checked for that and this is not the case here. In case you’re asking, the test to do is a Zonulin test in stool.
I left the slide on the microscope and checked after a few days:
It had more colorful lights (not blinking), so on the other hand it could be a mesogen as well. In any case I will need to continue the EDTA and Vitamin C and check again.
If you would like to support my work and help pay for the costs of doing this research, you can become a paid subscriber or buy me a coffee.
One-time or recurring donations can be made through Ko-Fi:
Paid subscribers receive the same information as free subscribers as I want the information to be available to everybody. The perks I can offer paid subscribers are special discount codes for my bookstore and occasional discounts on products from www.biorica.biz. Paid subscribers receive a separate email with the coupon codes. Paid subscribers also receive a chapter every other week from my book Awaken To Your Power.
I leave the comment section open so everybody can communicate and comment with each other, but I’m not always able to read them.

you need to purify your body with chlorine dioxides injections, I've used three doses which are three drops 30 cc's to 60 cc's of distilled water solution.. take it orally three drops every hour that you are awake in a 24-hour day for 28 days. you can do more research at chlorine dioxide testimonies on telegram, I use EDTA vitamin C and chlorine dioxide. I have Olympics bh2 full oil immersion dark field microscope that I work with on a daily basis and have for the last 4 years. best wishes.
Has the fort lauderdale clinic opened..